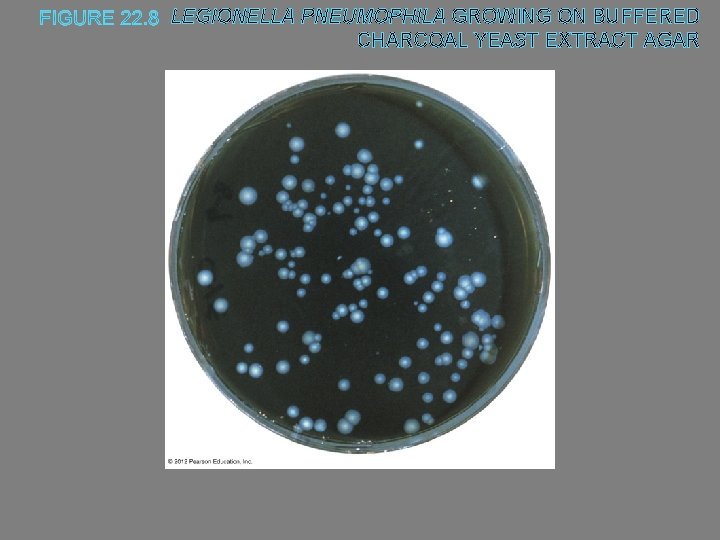
LEGIONELLA PNEUMOPHILA GROWING ON BUFFERED CHARCOAL YEAST EXTRACT AGAR

Chapter 22 Microbial Diseases of the Respiratory System

Chapter 22 Microbial Diseases of the Respiratory System

Structures of the Respiratory System Respiratory system exchanges gases between the atmosphere and the blood Divided into two main parts Upper respiratory system Lower respiratory system © 2012 Pearson Education Inc.

Structures of the Upper Respiratory System, Sinuses, and Ears Components of the upper respiratory system ○ Nose ○ Nasal cavity ○ Pharynx ○ Tonsils ○ Mucus © 2012 Pearson Education Inc. Components of the lower respiratory system ○ Larynx ○ Trachea ○ Bronchi ○ Alveoli ○ Diaphragm ○ Various protective components Ciliated mucous membrane, alveolar macrophages, and secretory antibodies

FIGURE 22. 1 STRUCTURES OF THE RESPIRATORY SYSTEM-OVERVIEW

Normal Microbiota of the Respiratory System Lower respiratory system ○ Typically microorganisms are not present - Might have found evidence that this is not necessarily true Upper respiratory system ○ Colonized by many microorganisms ○ Normal microbiota limit growth of pathogens ○ Normal microbiota may be opportunistic pathogens © 2012 Pearson Education Inc.

Bacterial Diseases of the Upper Respiratory System, Sinuses, and Ears Streptococcal Respiratory Diseases Signs and symptoms ○ Sore throat and difficulty swallowing ○ May progress to scarlet or rheumatic fever (heart damage) Pathogen and virulence factors ○ Caused by group A streptococci (S. pyogenes) ○ Variety of virulence factors M proteins and C 5 a peptidase – interfere with complement hyaluronic acid capsule – camouflauge streptokinases – breaks down blood clots pyrogenic toxin – stimulate fever, rash (scarlet fever), shock streptolysins – lyse erythrocytes and leukocytes © 2012 Pearson Education Inc.

Streptococcal Respiratory Diseases Pathogenesis ○ Occurs when normal microbiota are depleted, large inoculum is introduced, or adaptive immunity is impaired Epidemiology ○ Spread via respiratory droplets ○ Occurs most often in winter and spring Diagnosis, treatment, and prevention ○ Often confused with viral pharyngitis ○ Penicillin is an effective treatment © 2012 Pearson Education Inc.

Diphtheria Signs and symptoms ○ Presence of a pseudomembrane that can obstruct airways - Oozing thick fluid compiled of dead cells Pathogen and virulence factors ○ Caused by Corynebacterium diphtheriae ○ Virulence factors C. diptheriae produces diphtheria toxin which enters into cells - Prevents polypeptide synthesis and causes cell death © 2012 Pearson Education Inc.

FIGURE 22. 2 A PSEUDOMEMBRANE, CHARACTERISTIC OF DIPHTHERIA

Diphtheria Pathogenesis and epidemiology ○ Spread via respiratory droplets or skin contact ○ Symptomatic in immunocompromised or nonimmune individuals Diagnosis, treatment, and prevention ○ Diagnosis based on presence of a pseudomembrane ○ Treat with antitoxin and antibiotics ○ Immunization is an effective prevention © 2012 Pearson Education Inc.

Sinusitis and Otitis Media Signs and symptoms ○ Sinusitis causes pain and pressure of the affected sinus accompanied by malaise ○ Otitis media results in severe pain in the ears Pathogen and virulence factors ○ Caused by various respiratory microbiota May be due to upper respiratory system and auditory tube damage © 2012 Pearson Education Inc.

Sinusitis and Otitis Media Pathogenesis and epidemiology ○ Bacteria in the pharynx spread to the sinuses via the throat ○ Sinusitis is more common in adults ○ Otitis media is more common in children - This is because their Eustachian tubes are more horizontal and smaller Diagnosis, treatment, and prevention ○ Symptoms often diagnostic ○ No known way to prevent sinusitis © 2012 Pearson Education Inc.

Viral Diseases of the Upper Respiratory System Common Cold Signs and symptoms ○ Sneezing, runny nose, congestion, sore throat, malaise, and cough Pathogens and virulence factors ○ Enteroviruses (rhinoviruses) are the most common cause ○ Numerous other viruses cause colds Pathogenesis ○ Cold viruses replicate in and then kill infected cells ○ Only upper respiratory Don’t grow in warmth of lower respiratory system, cannot withstand acidity of stomach © 2012 Pearson Education Inc.

FIGURE 22. 4 RHINOVIRUSES, THE MOST COMMON CAUSE OF COLDS

Common Cold Epidemiology ○ Rhinoviruses are extremely infective – single virus is enough to infect 50% of infected individuals ○ Spread by coughing/sneezing, fomites, or person-to-person contact Diagnosis, treatment, and prevention ○ Signs and symptoms are usually diagnostic ○ Pleconaril can reduce duration of symptoms ○ Hand antisepsis is important preventive measure © 2012 Pearson Education Inc.

Bacterial Diseases of the Lower Respiratory System Bacterial infection of the lower respiratory system can cause lifethreatening illness © 2012 Pearson Education Inc.

Bacterial Pneumonias Lung inflammation accompanied by fluid– filled alveoli and bronchioles Bacterial pneumonias are the most serious and the most frequent in adults © 2012 Pearson Education Inc.

Pneumoccocal Pneumonia Signs and symptoms ○ Short, rapid breathing; rust-colored sputum Pathogen and virulence factors ○ Caused by Streptococcus pneumoniae ○ Virulence factors include adhesins, capsule, pneumolysin (binds to cholesterol on cell membranes) Pathogenesis and epidemiology ○ Infection occurs by inhalation of bacteria ○ Bacterial replication causes damage to the lungs Diagnosis, treatment, and prevention ○ Penicillin is the drug of choice for treatment ○ Vaccination is method of prevention © 2012 Pearson Education Inc.

FIGURE 22. 5 STREPTOCOCCUS PNEUMONIAE, THE MOST COMMON CAUSE OF BACTERIAL PNEUMONIA Capsule

Primary Atypical (Mycoplasmal) Pneumonia Signs and symptoms ○ Include fever, malaise, sore throat, excessive sweating ○ Excessive cough ○ Usually not bad enough to hospitalized – “walking pneumonia” Pathogen and virulence factors ○ Caused by Mycoplasma pneumoniae ○ Virulence factors include an adhesion protein Epidemiology ○ Bacteria spread by nasal secretions Diagnosis, treatment, and prevention ○ Treated with tetracycline and erythromycin ○ Prevention difficult since infected individuals may be asymptomatic © 2012 Pearson Education Inc.

Klebsiella Pneumonia Signs and symptoms ○ Pneumonia symptoms combined with a thick, bloody sputum Pathogen and virulence factors ○ Caused by Klebsiella pneumoniae ○ Virulence factors include a capsule Pathogenesis and epidemiology ○ Immunocompromised individuals at greatest risk for infection - Elderly, children, AIDS patients Diagnosis, treatment, and prevention ○ Treated with antimicrobials ○ Prevention involves good aseptic technique by health care workers © 2012 Pearson Education Inc.

FIGURE 22. 7 THE PROMINENT CAPSULE OF KLEBSIELLA PNEUMONIAE Capsules

Other Bacterial Pneumonias Haemophilus influenzae and Staphylococcus aureus ○ Disease similar to pneumococcal pneumonia Yersinia pestis ○ Causes pneumonia called pneumonic plague Chlamydophila psittaci ○ Causative agent of ornithosis Disease of birds that can be transmitted to humans Chlamydophila pneumoniae ○ Causes pneumonia, bronchitis, and sinusitis © 2012 Pearson Education Inc.

Legionnaires’ Disease Signs and symptoms ○ Typical pneumonia symptoms Pulmonary function can rapidly decrease, complications with central nervous system and kidneys can happen Pathogen and virulence factors ○ Most cases caused by Legionella pneumophila Pathogenesis ○ L. pneumophila kills human cells Causes tissue damage and inflammation © 2012 Pearson Education Inc.
LEGIONELLA PNEUMOPHILA GROWING ON BUFFERED CHARCOAL YEAST EXTRACT AGAR

Legionnaires’ Disease Epidemiology ○ Legionella survives in domestic water sources ○ The elderly, smokers, and immunocompromised individuals are at increased risk for infection Diagnosis, treatment, and prevention ○ Diagnosed with fluorescent antibody staining or serology ○ Quinolones or macrolides are the preferred treatment ○ Control by reducing bacterial presence in water © 2012 Pearson Education Inc.

Tuberculosis Signs and symptoms ○ Symptoms not always initially apparent Pathogen and virulence factors ○ Caused by Mycobacterium tuberculosis ○ Presence of mycolic acid gives bacteria unique features Pathogenesis ○ M. tuberculosis remains viable for long time in aerosol drops © 2012 Pearson Education Inc.

FIGURE 22. 9 THE PROCESSES INVOLVED IN THE DEVELOPMENT OF TUBERCULOSIS IN THE LUNGS-OVERVIEW

Tuberculosis Epidemiology ○ Immunocompromised individuals are most at risk ○ Tuberculosis is leading killer of HIV+ individuals Diagnosis, treatment, and prevention ○ Tuberculin skin test identifies exposure to tuberculosis ○ Chest X-rays can identify tubercles in the lungs ○ Treatment requires combination of drugs ○ Drug-resistant strains of M. tuberculosis have emerged ○ BCG vaccine available where tuberculosis is common © 2012 Pearson Education Inc.

DIAGNOSIS OF TUBERCULOSIS-OVERVIEW

Pertussis (Whooping Cough) Signs and symptoms ○ Initially coldlike, then characteristic cough develops Pathogen and virulence factors ○ Bordetella pertussis is the causative agent ○ Produces numerous virulence factors Includes adhesins and several toxins which can cause increased mucus production and constriction Pathogenesis ○ Pertussis progresses through four phases Incubation, catarrhal (common cold), paroxysmal (violent cough for weeks), and convalescent © 2012 Pearson Education Inc.

Pertussis (Whooping Cough) Epidemiology ○ Highly contagious ○ Bacteria spread through the air in airborne droplets Diagnosis, treatment, and prevention ○ Symptoms are usually diagnostic ○ Treatment is primarily supportive ○ Prevention is with the DTa. P vaccine © 2012 Pearson Education Inc.

Inhalational Anthrax Signs and symptoms ○ Initially resembles a cold or flu ○ Progresses to severe coughing, lethargy, shock, and death Pathogen and virulence factors ○ Bacillus anthracis is the causative agent ○ Virulence factors include a capsule and anthrax toxin Pathogenesis and epidemiology ○ Anthrax not spread from person to person ○ Acquired by contact or inhalation of endospores © 2012 Pearson Education Inc.

Inhalation Anthrax Diagnosis, treatment, and prevention ○ Diagnosis based on identification of bacteria in sputum ○ Early and aggressive antimicrobial treatment necessary ○ Anthrax vaccine available to select individuals © 2012 Pearson Education Inc.

Viral Diseases of the Lower Respiratory System Influenza Signs and symptoms ○ Sudden fever, pharyngitis, congestion, cough, myalgia Pathogens and virulence factors ○ Influenza virus types A and B are the causative agents ○ Mutations in hemagglutinin and neuraminidase produce new strains Occurs via antigenic drift and antigenic shift © 2012 Pearson Education Inc.

FIGURE 22. 12 INFLUENZAVIRUS BUDDING FROM A CELL Neuraminidase Hemagglutinin Envelope ss. RNA molecule in helical capsid

THE DEVELOPMENT OF NEW STRAINS OF FLU VIRUSESOVERVIEW

Influenza Pathogenesis ○ Symptoms are a result of the immune response to the virus ○ Flu patients are susceptible to secondary bacterial infections Virus causes damage to the lung epithelium Epidemiology ○ Transmitted via inhalation of viruses or by selfinoculation ○ Complications occur most often in the elderly, children, and individuals with chronic diseases © 2012 Pearson Education Inc.

Influenza Diagnosis, treatment, and prevention ○ Signs and symptoms during a community-wide outbreak are often diagnostic ○ Treatment involves supportive care to relieve symptoms ○ Oseltamivir and zanamivir can be administered early in infection ○ Prevent by immunization with a multivalent vaccine © 2012 Pearson Education Inc.

Severe Acute Respiratory Syndrome (SARS) Signs and symptoms ○ High fever, shortness of breath, and difficulty breathing ○ Later develop dry cough and pneumonia Pathogen and virulence factors ○ Caused by a coronavirus called SARS virus Pathogenesis and epidemiology ○ SARS virus spreads via respiratory droplets Diagnosis, treatment, and prevention ○ Diagnosis based on signs and symptoms of SARS ○ Treatment is supportive © 2012 Pearson Education Inc.

Respiratory Syncytial Virus (RSV) Infection Most common childhood respiratory disease Signs and symptoms ○ Fever, runny nose, and coughing in babies or immunocompromised individuals ○ Mild coldlike symptoms in older children and adults Pathogen ○ Respiratory syncytial virus (RSV) Pathogenesis ○ Virus causes syncytia to form in the lungs Giant, multi-nucleated cell formed from fusion of virally infected cells with neighboring cells ○ Immune response to RSV further damages the lungs © 2012 Pearson Education Inc.


Respiratory Syncytial Virus Infection Epidemiology ○ Transmission occurs via close contact with infected persons Diagnosis, treatment, and prevention ○ Diagnosis made by immunoassay ○ Supportive treatment for young children ○ Prevention includes aseptic technique of health care and day care employees © 2012 Pearson Education Inc.

Hantavirus Pulmonary Syndrome (HPS) Signs and symptoms ○ Symptoms progress to cough, shock, and labored breathing Pathogen ○ Caused by Hantavirus ○ Transmitted from mice via inhalation Pathogenesis ○ Infection causes widespread inflammation leading to shock © 2012 Pearson Education Inc.


Hantavirus Pulmonary Syndrome (HPS) Epidemiology ○ Human disease more likely as mouse population increases ○ Person-to-person contact does not occur Diagnosis, treatment, and prevention ○ Diagnosis made based on characteristic symptoms ○ No specific treatment is available ○ Prevention requires control of rodents © 2012 Pearson Education Inc.

Other Viral Respiratory Diseases Other viruses cause respiratory disease in children, the elderly, or immunocompromised individuals ○ Cytomegalovirus - Most people do not know they have it; poses problem in pregnant individuals or individuals that are immunocomprimised ○ Metapneumovirus Estimated to be the second most common cause of viral respiratory disease compared to rhinoviruses Most people have antibodies ○ Parainfluenza viruses Three strains cause croup and viral pneumonia Occur primarily in young children © 2012 Pearson Education Inc.

Mycoses of the Lower Respiratory System Coccidioidomycosis Signs and symptoms ○ Resembles pneumonia or tuberculosis ○ Can become systemic in immunocompromised persons Pathogen and virulence factors ○ Caused by Coccidioides immitis ○ Pathogen assumes yeast form at human body temperature Pathogenesis ○ Arthroconidia from the soil enter the body through inhalation © 2012 Pearson Education Inc.

COCCIDIOIDOMYCOSIS LESIONS IN SUBCUTANEOUS TISSUE

FIGURE 22. 19 SPHERULES OF COCCIDIOIDES IMMITIS Spherule Spores

Coccidioidomycosis Epidemiology ○ Almost exclusively in southwestern U. S. and northern Mexico Diagnosis, treatment, and prevention ○ Diagnosed by presence of spherules in clinical specimens ○ Treat with amphotericin B ○ Protective masks can prevent exposure to arthroconidia © 2012 Pearson Education Inc.

Blastomycosis Signs and symptoms ○ Flulike symptoms ○ Systemic infections can produce lesions on the face and upper body or purulent lesions on various organs Pathogen ○ Caused by Blastomyces dermatitidis ○ Pathogenic yeast form at human body temperature © 2012 Pearson Education Inc.

CUTANEOUS BLASTOMYCOSIS IN AN AMERICAN WOMAN

Blastomycosis Pathogenesis and epidemiology ○ Enters body through inhalation of dust carrying fungal spores ○ Incidence of human infection is increasing Diagnosis, treatment, and prevention ○ Diagnosis based on fungus identification in clinical samples ○ Treated with amphotericin B ○ Relapse common in AIDS patients © 2012 Pearson Education Inc.

Histoplasmosis Signs and symptoms ○ Asymptomatic in most cases ○ Symptomatic infection causes coughing with bloody sputum or skin lesions Pathogen ○ Caused by Histoplasmosis capsulatum ○ Pathogenic yeast form at human body temperature © 2012 Pearson Education Inc.

Histoplasmosis Pathogenesis and epidemiology ○ Humans inhale airborne spores from the soil ○ Prevalent in the eastern U. S. Diagnosis, treatment, and prevention ○ Diagnosis based on fungus identification in clinical samples ○ Infections in immunocompetent individuals typically resolve without treatment © 2012 Pearson Education Inc.

Pneumocystis Pneumonia (PCP) Signs and symptoms ○ Difficulty breathing, anemia, hypoxia, and fever Pathogen ○ Caused by Pneumocystis jirovecii Pathogenesis and epidemiology ○ Transmitted by inhalation of droplets containing the fungus ○ Common disease in AIDS patients Almost diagnostic for AIDS Diagnosis, treatment, and prevention ○ Diagnosis based on clinical and microscopic findings ○ Treat with trimethoprim and sulfamethoxazole ○ Impossible to prevent infection with P. jirovecii © 2012 Pearson Education Inc.

FIGURE 22. 21 CYSTS OF PNEUMOCYSTIS JIROVECII IN LUNG TISSUE Cyst
- Slides: 58